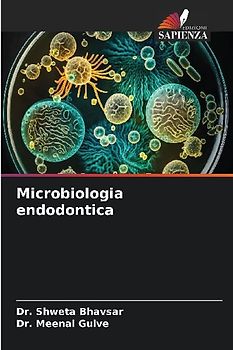
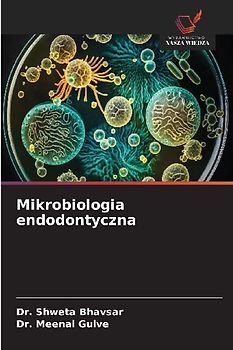
Mikrobiologia endodontyczna

Gebrauchte Bücher von Gulve, Meenal bei rebuy
… Von Expert:innen geprüfte Gulve, Meenal-Bücher. Entdecke unsere Riesenauswahl und bestelle ohne Risiko. Nachhaltig und günstig!
… Von Expert:innen geprüfte Gulve, Meenal-Bücher. Entdecke unsere Riesenauswahl und bestelle ohne Risiko. Nachhaltig und günstig!

Microbiologia endodontica
Nur als Neuware

Microbiologie endodontique
Nur als Neuware

Carie dentale e sua prevenzione
Nur als Neuware

Endodontische Mikrobiologie
Nur als Neuware

ENDODONTIC MICROBIOLOGY
Nur als Neuware

Microscopes in Endodontics
Nur als Neuware

APICAL PERIODONTITIS IN OBTURATED TEETH
Nur als Neuware

Urgences endodontiques
Nur als Neuware

Emergenze endodontiche
Nur als Neuware

Techniques Of Bio-mechanical Preparation
Nur als Neuware

Cast Gold Restoration
Nur als Neuware

Porcelain Laminate Veneers
Nur als Neuware

Endodontische Notfälle
Nur als Neuware

Determinación de la longitud de trabajo en endodoncia
Nur als Neuware

Diagnosis of Dental Caries
Nur als Neuware

Próchnica z¿bów i jej zapobieganie

Microbiología endodóntica

La carie dentaire et sa prévention

Zahnkaries und ihre Vorbeugung

Caries dental y su prevención

Rola PRF w endodoncji regeneracyjnej

Ruolo della PRF nell'endodonzia rigenerativa

Papel del PRF en endodoncia regenerativa

SMART MATERIALS IN DENTISTRY

DENTAL CARIES AND ITS PREVENTION
Lieber Geld verdienen als ausgeben?
Verkauf Elektronik und Medien ganz einfach an uns
Versand immer kostenlos und versichert 100 % Löschung deiner Daten Erfahrung und Sicherheit seit 2004
Der Streichpreis bezieht sich auf die unverbindliche Preisempfehlung des Herstellers, den aktuellen durchschnittlichen Neupreis des Produktes bei idealo Deutschland, oder bei Büchern auf den festgelegten Preis für Neuware.